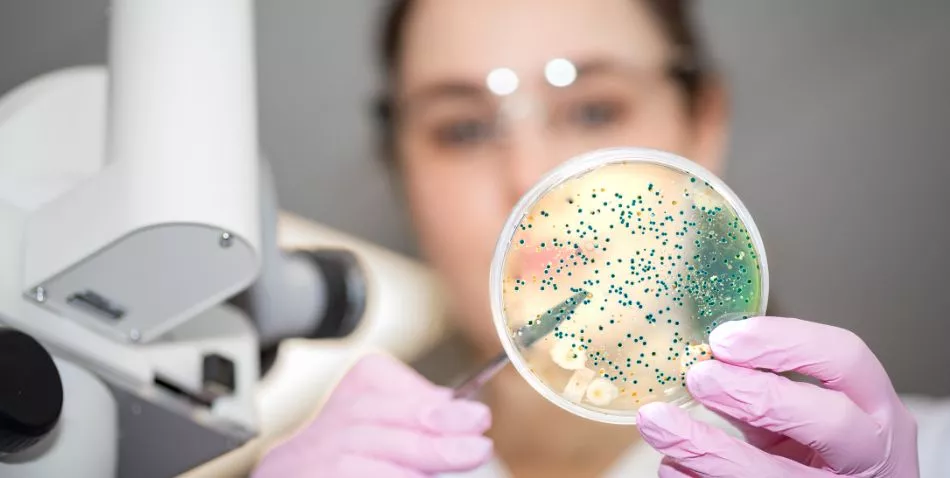

1. Introducción
Detrás de cada planta de biogás hay un ejército que nadie ve: microorganismos especializados que transforman residuos orgánicos en energía renovable y fertilizante natural. Su labor, silenciosa y constante, es esencial para cerrar ciclos sostenibles en el campo, en la industria agroganadera y en las comunidades rurales y urbanas vinculadas a la gestión responsable de los residuos.
Estos microorganismos trabajan de manera coordinada, descomponiendo la materia orgánica, estabilizando los residuos, eliminando malos olores y reduciendo emisiones contaminantes. Gracias a su actividad, los residuos que tradicionalmente suponían un problema ambiental se convierten en una fuente estable de energía limpia y en recursos agronómicos de alto valor.
El objetivo de este artículo es explicar de forma detallada cómo funcionan estos organismos, por qué son fundamentales en la producción de biogás y de qué manera su actividad aporta beneficios ambientales, sociales y económicos. A lo largo del texto se pone en valor el papel clave de la digestión anaerobia como tecnología madura, eficiente y positiva, capaz de transformar residuos en oportunidades y de contribuir de manera decisiva a un modelo energético y productivo sostenible.

2. Microorganismos en acción
2.1 Diversidad microbiana en los digestores
Un digestor anaerobio alberga una comunidad diversa y altamente especializada de microorganismos. Entre ellos se encuentran bacterias hidrolíticas, bacterias acidogénicas, bacterias acetogénicas y arqueas metanogénicas. Cada uno de estos grupos desempeña funciones específicas y complementarias que permiten la transformación progresiva de los residuos orgánicos complejos en biogás y digestato estabilizado.
Las bacterias hidrolíticas inician el proceso descomponiendo polímeros complejos como carbohidratos, proteínas y lípidos. Las bacterias acidogénicas continúan el proceso transformando los productos de la hidrólisis en compuestos más simples. Posteriormente, las bacterias acetogénicas convierten estos compuestos en precursores directos del metano. Finalmente, las arqueas metanogénicas producen el metano que constituye el principal componente energético del biogás.
Esta diversidad microbiana convierte al digestor en un ecosistema dinámico, equilibrado y altamente eficiente, capaz de adaptarse a diferentes tipos de residuos y condiciones de operación.
2.2 Etapas de la digestión anaerobia
La digestión anaerobia se desarrolla en una serie de etapas claramente definidas, todas ellas impulsadas por la acción de los microorganismos.
Hidrólisis: en esta fase se produce la descomposición de compuestos complejos como carbohidratos, proteínas y grasas en moléculas más simples, solubles y accesibles para los microorganismos posteriores.
Acidogénesis: los productos de la hidrólisis se convierten en ácidos grasos volátiles, alcoholes, hidrógeno y dióxido de carbono, generando un sustrato energético clave para las siguientes fases.
Acetogénesis: los ácidos grasos y alcoholes se transforman en acetato, hidrógeno y dióxido de carbono, compuestos esenciales para la producción de metano.
Metanogénesis: las arqueas metanogénicas convierten el acetato y el hidrógeno en metano y CO₂, dando lugar al biogás aprovechable.
Cada una de estas etapas depende de la acción coordinada de diferentes grupos microbianos, que funcionan como un equipo altamente especializado y sincronizado.
2.3 Sincronización y cooperación microbiana
La eficiencia de un digestor anaerobio depende directamente de que todos los microorganismos trabajen en armonía. La cooperación entre bacterias y arqueas es fundamental para mantener un equilibrio estable y una producción constante de biogás.
La alteración de alguna etapa puede afectar al rendimiento global del sistema. Por este motivo, la monitorización continua de parámetros como el pH, la temperatura, la carga orgánica y la mezcla resulta esencial para mantener la salud de la comunidad microbiana y garantizar su máximo rendimiento.
3. Condiciones óptimas para el “ejército invisible”
3.1 Temperatura y régimen de operación
Los microorganismos requieren condiciones térmicas estables para desarrollar su actividad de forma óptima. Los regímenes mesófilos, con temperaturas comprendidas entre 35 y 37 °C, son los más habituales y proporcionan una gran estabilidad al proceso.
Por su parte, los regímenes termófilos, con temperaturas entre 50 y 55 °C, permiten acelerar la digestión, aumentar la velocidad de producción de biogás y contribuir a la reducción de patógenos. Ambos regímenes ofrecen resultados positivos cuando se gestionan adecuadamente.
3.2 pH y nutrientes esenciales
Un pH ligeramente neutro favorece la actividad metabólica de la mayoría de bacterias y arqueas presentes en el digestor. El control del pH es una herramienta clave para asegurar la estabilidad del proceso.
Además, la disponibilidad de nutrientes como nitrógeno, fósforo, potasio y oligoelementos garantiza un metabolismo microbiano eficiente y continuo. Un equilibrio adecuado de estos elementos permite maximizar la producción de biogás y la calidad del digestato.
3.3 Mezcla y oxigenación controlada
La mezcla homogénea del contenido del digestor asegura que los microorganismos tengan acceso constante a los nutrientes y evita la formación de capas o sedimentos que podrían limitar su actividad. La ausencia total de oxígeno es igualmente crucial, ya que la digestión anaerobia se desarrolla exclusivamente en condiciones anaerobias.
4. De la acción microbiana a la energía

4.1 Transformación de residuos
Los microorganismos convierten residuos orgánicos como purines, estiércoles, subproductos agroindustriales y restos vegetales en una mezcla gaseosa rica en metano. Este proceso permite valorizar residuos locales y transformarlos en una fuente estable de energía renovable.
4.2 Producción de electricidad y calor
El metano contenido en el biogás se utiliza como combustible en motores de cogeneración o turbinas para producir electricidad y calor. La electricidad puede destinarse al autoconsumo, a comunidades energéticas o a la red eléctrica, mientras que el calor se aprovecha en calefacción, procesos industriales o secado.
Este aprovechamiento conjunto incrementa la eficiencia energética de las plantas de biogás y maximiza el valor generado por la actividad microbiana.
4.3 Digestato: subproducto valioso
El digestato resultante del proceso es un fertilizante natural rico en nutrientes, estable y fácilmente asimilable por los cultivos. Su uso contribuye a mejorar la fertilidad del suelo, cerrar ciclos de nutrientes y reducir la dependencia de fertilizantes minerales.

5. Beneficios ambientales del ejército invisible
5.1 Reducción de emisiones contaminantes
La digestión anaerobia captura el metano que se liberaría de forma natural durante la descomposición de los residuos, reduciendo de manera significativa las emisiones de gases de efecto invernadero y contribuyendo a la protección del clima.
5.2 Eliminación de malos olores
El tratamiento de residuos en digestores anaerobios reduce de forma notable los olores asociados a purines y estiércoles, mejorando la convivencia entre explotaciones agroganaderas y núcleos de población cercanos.
5.3 Contribución a la economía circular
La producción de energía renovable y fertilizante a partir de residuos locales impulsa un modelo de economía circular, en el que los recursos se reutilizan y se aprovechan de forma eficiente y sostenible.
5.4 Fortalecimiento de comunidades rurales
Las plantas de biogás generan oportunidades económicas, reducen costes energéticos y fomentan la autosuficiencia, contribuyendo al desarrollo y la estabilidad de las comunidades rurales.
6. Casos prácticos y aplicaciones
6.1 Granjas autosuficientes
Numerosas explotaciones han logrado cubrir su demanda energética mediante digestores anaerobios, demostrando la viabilidad técnica y económica del biogás y el valor del trabajo microbiano.
6.2 Cooperativas y plantas centralizadas
Las plantas de mayor escala permiten agrupar residuos de varias explotaciones, aumentar la eficiencia y generar beneficios compartidos, reforzando el tejido cooperativo y territorial.
6.3 Innovaciones y monitoreo digital
Las tecnologías de control y monitorización permiten seguir en tiempo real la actividad microbiana, ajustar parámetros y asegurar un funcionamiento estable, eficiente y seguro.
7. Retos y soluciones
7.1 Variabilidad de residuos
La correcta planificación y caracterización de los residuos garantiza la estabilidad del proceso y permite a los microorganismos adaptarse de forma eficiente.
7.2 Formación y gestión técnica
La capacitación del personal asegura una gestión adecuada del digestor y un aprovechamiento óptimo del potencial microbiano.
7.3 Optimización futura
La investigación continua permite mejorar la eficiencia del proceso, reforzar la resiliencia microbiana y aumentar la producción de energía y fertilizante.
8. Perspectivas de futuro
8.1 Ampliación de la tecnología
La digestión anaerobia puede aplicarse a distintas escalas, ampliando su impacto positivo en múltiples territorios.
8.2 Innovaciones biotecnológicas
El desarrollo de cepas optimizadas, sensores avanzados y sistemas automatizados permitirá un aprovechamiento aún más eficiente de los residuos.
8.3 Biogás como motor rural
El biogás se consolida como una herramienta clave para la sostenibilidad, la independencia energética y el desarrollo equilibrado del medio rural.
9. Conclusiones
Los microorganismos que trabajan día y noche en los digestores anaerobios transforman residuos en energía renovable, fertilizante natural y bienestar para las comunidades. Este “ejército invisible” demuestra que la combinación de naturaleza y tecnología ofrece soluciones eficaces, positivas y sostenibles.
Gracias a su acción, los residuos se convierten en oportunidades y el biogás se posiciona como una energía renovable estratégica, capaz de generar beneficios ambientales, sociales y económicos de forma continuada.

Bibliografía
Angelidaki, I., & Ellegaard, L. (2003). Codigestion of manure and organic wastes in centralized biogas plants. Applied Biochemistry and Biotechnology, 109(1–3), 95–105.
Weiland, P. (2010). Biogas production: Current state and perspectives. Applied Microbiology and Biotechnology, 85(4), 849–860.
Holm-Nielsen, J. B., Al Seadi, T., & Oleskowicz-Popiel, P. (2009). The future of anaerobic digestion and biogas utilization. Bioresource Technology, 100(22), 5478–5484.
Mata-Alvarez, J. (2003). Biological Wastewater Treatment: Principles, Modelling and Design. IWA Publishing.
European Biogas Association. (2020). Statistical Report 2020.

